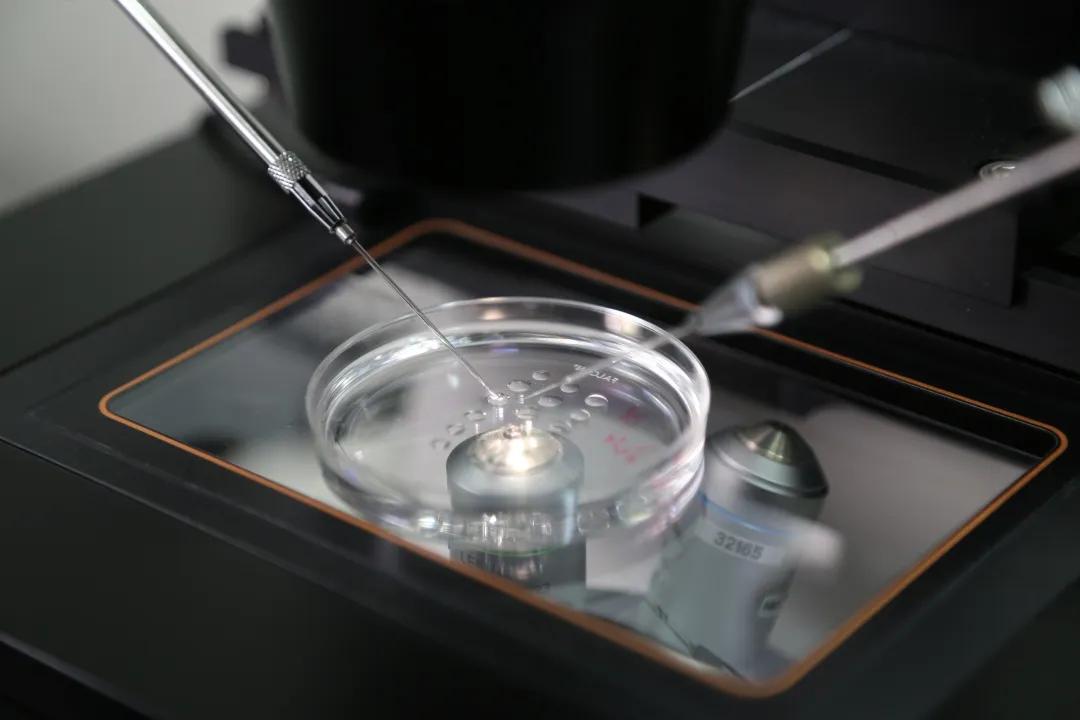
试管婴儿胚胎移植一次成功的几率,试管婴儿移植失败胚胎去哪里了

闫女士和丈夫一直想要二胎,但尝试了两年没有成功。2017年,夫妻俩来到徐州市妇幼保健院生殖医学中心,向中心主任黄晓洁求助。随后,两人选择了第二代试管婴儿技术助孕,但种植多个胚胎均失败。经过子宫内膜容受性检测(ERA)技术检测发现,闫女士的子宫内膜种植窗发生了后移。黄晓洁主任根据检测结果及时调整了移植策略,种植了1枚优质囊胚,使闫女士成功受孕。今年4月,闫女士成功产下重7斤8两的健康宝宝。
真实病例
闫女士和丈夫结婚多年,有一个活泼可爱的儿子。二孩政策放开后,两人一直想再生个孩子,但努力两年无果。2017年,夫妻俩来到徐州市妇幼保健院生殖医学中心向中心主任黄晓洁求助。检查发现,张女士因输卵管堵塞导致继发性不孕。
黄晓洁主任介绍,当时闫女士和丈夫选择了第二代试管婴儿技术。张女士促排卵后,获得了8个成熟的卵母细胞,受精以后,形成6个高评分胚胎。但移植了三次,都没有成功,被诊断为反复种植失败。
“反复种植失败,与女方年龄偏大及子宫内膜容受性有关。”黄晓洁主任说,影响胚胎种植的有三个因素,一是胚胎的问题,二是子宫内膜的问题,最后就是同步性的问题。她解释,胚胎种植是胚胎通过与子宫内膜相互作用连接于母体的子宫内膜,进而形成胎盘,实现母体与胚胎在结构和功能上的联系的过程。其过程主要包括胚胎粘附、迁移、侵入子宫内膜着床三个过程。人类辅助生殖技术(ART)的成熟保证了试管婴儿技术的成功率,给不孕不育症患者带来希望。
黄晓洁主任介绍,子宫内膜容受性较差是导致胚胎着床失败的重要原因之一。反复种植失败(RIF)就是接受人类辅助生殖助孕患者已经接受过连续多次的胚胎移植均无法成功妊娠的情况。RIF在体外受精-胚胎移植(IVF-ET)的发生率较高,其中约2/3的发生原因是子宫内膜容受性不良。因此,在子宫内膜容受性良好的时期进行种植是治疗反复种植失败、提高体外受精-胚胎移植临床妊娠率的可行方法之一。

及时调整
移植策略

“子宫内膜在特定时期才具有对胚胎的接受能力,称为种植窗(WOI)。”黄晓洁主任说,通常情况下,种植窗应该在排卵后的约6-10天,正常月经周期的约22-24天,持续约48小时。
但种植窗出现的时间存在个体差异,按照统一的标准推算种植窗可能会导致部分患者在子宫形态学和组织学完全正常的情况下接受优质胚胎种植时不能着床。徐州市妇幼保健院生殖医学中心通过子宫内膜容受性分析ERA技术,为闫女士评估子宫内膜的容受状态,并成功为她找到种植窗。
“ERA利用第二代测序技术(NGS)分析多个子宫内膜容受性相关基因的表达,通过基因的表达状态,进而判断子宫内膜是否适合胚胎移植。这项技术具有较高的敏感性和特异性,它能够帮助受检者在进行胚胎移植前,较为准确地找到种植窗。”经过检测,黄晓洁主任发现,闫女士的子宫内膜种植窗发生了后移。
黄晓洁主任根据检查结果和20年丰富的生殖医学经验及时调整了移植策略。2019年的7月为闫女士移植了一枚优质囊胚,闫女士成功受孕。今年4月,闫女士成功产下重7斤8两的健康宝宝。闫女士和爱人激动地表示,徐州市妇幼保健院生殖医学中心是一个诞生奇迹的地方,让千千万万不孕不育家庭圆了生育梦想。


专家提醒

备孕女性要重视子宫内膜的健康!
黄晓洁主任说,人类辅助生殖技术(ART)在过去十年间有了巨大进步,然而仍然有相当一部分女性即使拥有染色体正常的囊胚却无法生育。子宫内膜的健康对于成功怀孕至关重要,子宫内膜的微环境稳态也是影响胚胎着床的关键因素。
近年来,人体菌群和宿主间广泛的相互作用被揭示,菌群结构与功能的研究成为热点。研究表明,子宫内膜上有细菌定植,内膜菌群的结构相对简单,对女性生殖健康有重要作用,影响细菌性阴道炎、HIV等性传染病、生育力和早产风险等。乳杆菌属(特别是卷曲乳杆菌)可产生乳酸,维持酸性环境,并生成H2O2抑制杂菌,与较低的炎症水平有关,乳杆菌属占绝对主导的菌群可能更健康。健康的子宫内膜上存在丰富的乳酸菌,使着床环境呈现弱酸性。
囊胚植入会引发一系列的免疫反应,异常的免疫应答会影响胚胎的着床和发育。子宫内膜菌群可通过调节免疫细胞影响胚胎着床和组织形态,具有稳定结构的子宫内膜菌群可与局部免疫系统的协调互作,对保持内膜稳态非常重要。
黄晓洁主任提醒,反复种植失败的不孕女性、原发性不孕的女性、子宫内膜状况不佳的女性(有过子宫内膜增生、子宫内膜炎症、子宫息肉、子宫粘连等病史)、想要知道自身合适移植时机的女性、优质胚胎较少的(如卵巢储备功能下降、高龄女性等),可以优先考虑选择子宫内膜容受性分析(ERA)技术。

生殖助孕中心简介

徐州市妇幼保健院生殖助孕中心是江苏省妇幼保健重点学科、徐州市临床重点专科,是江苏省苏北和苏中地区唯一具有第三代试管婴儿技术资质的单位。
生殖助孕中心成立于2001年,是徐州市最早开展“试管婴儿”技术的医疗单位,是淮海经济地区首批获原卫生部批准开展“体外受精/单精子卵浆内注射-胚胎移植”(第二代试管婴儿技术)等人类辅助生殖技术的医疗机构。2002年6月23日诞生了徐州市首例试管婴儿,标志着我市不孕不育治疗水平跨入了国内先进行列。2005年诞生了徐州市首例“冻融胚胎”试管婴儿。2010年诞生了徐州市首例“玻璃化冻融胚胎”试管婴儿,2014年诞生了淮海经济地区首例“卵母细胞冻融”试管婴儿,2014年诞生了淮海经济地区首例“未成熟卵母细胞体外培养成熟(IVM)”试管婴儿,2020年诞生了徐州市首例“第三代试管婴儿”,标志着我市人类辅助生殖与预防出生缺陷技术处于国内先进水平。近年来本中心的临床妊娠率稳定在>60%,居国内先进水平,目前已有多例接受PGT周期的患者成功获得妊娠。
通讯员 张彤
“原创文章,如需转载请提前告知。如发现私自转载者,追究法律责任。”